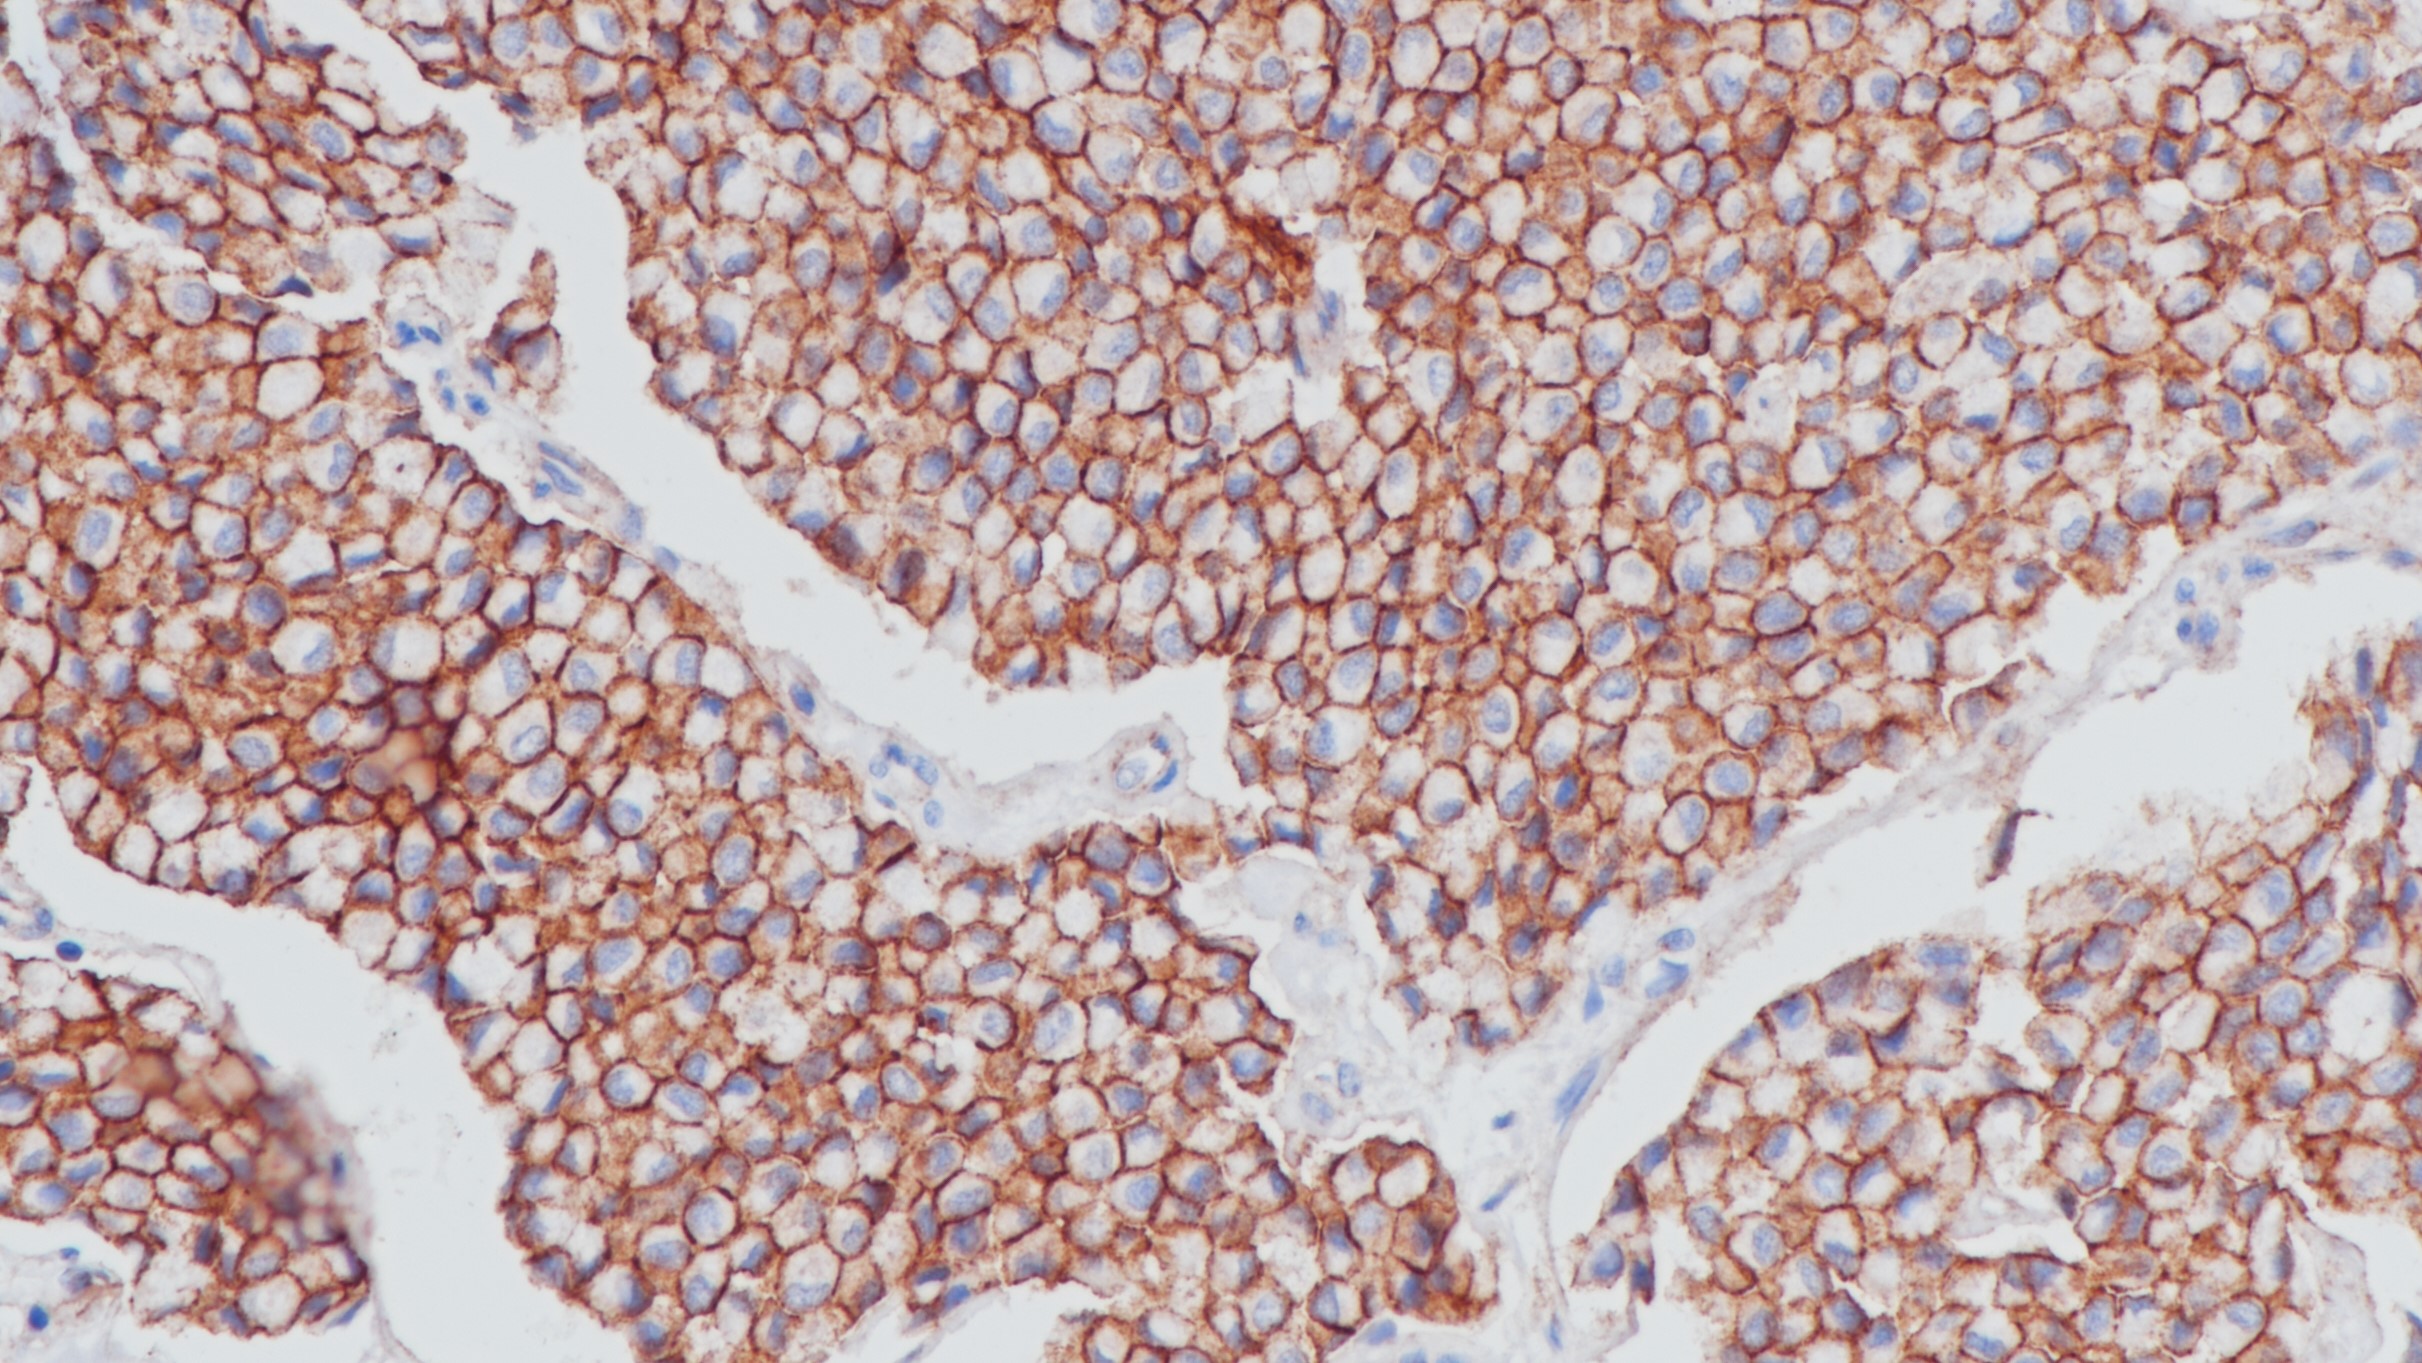
乳腺癌Beta-catenin(BP6159)染色
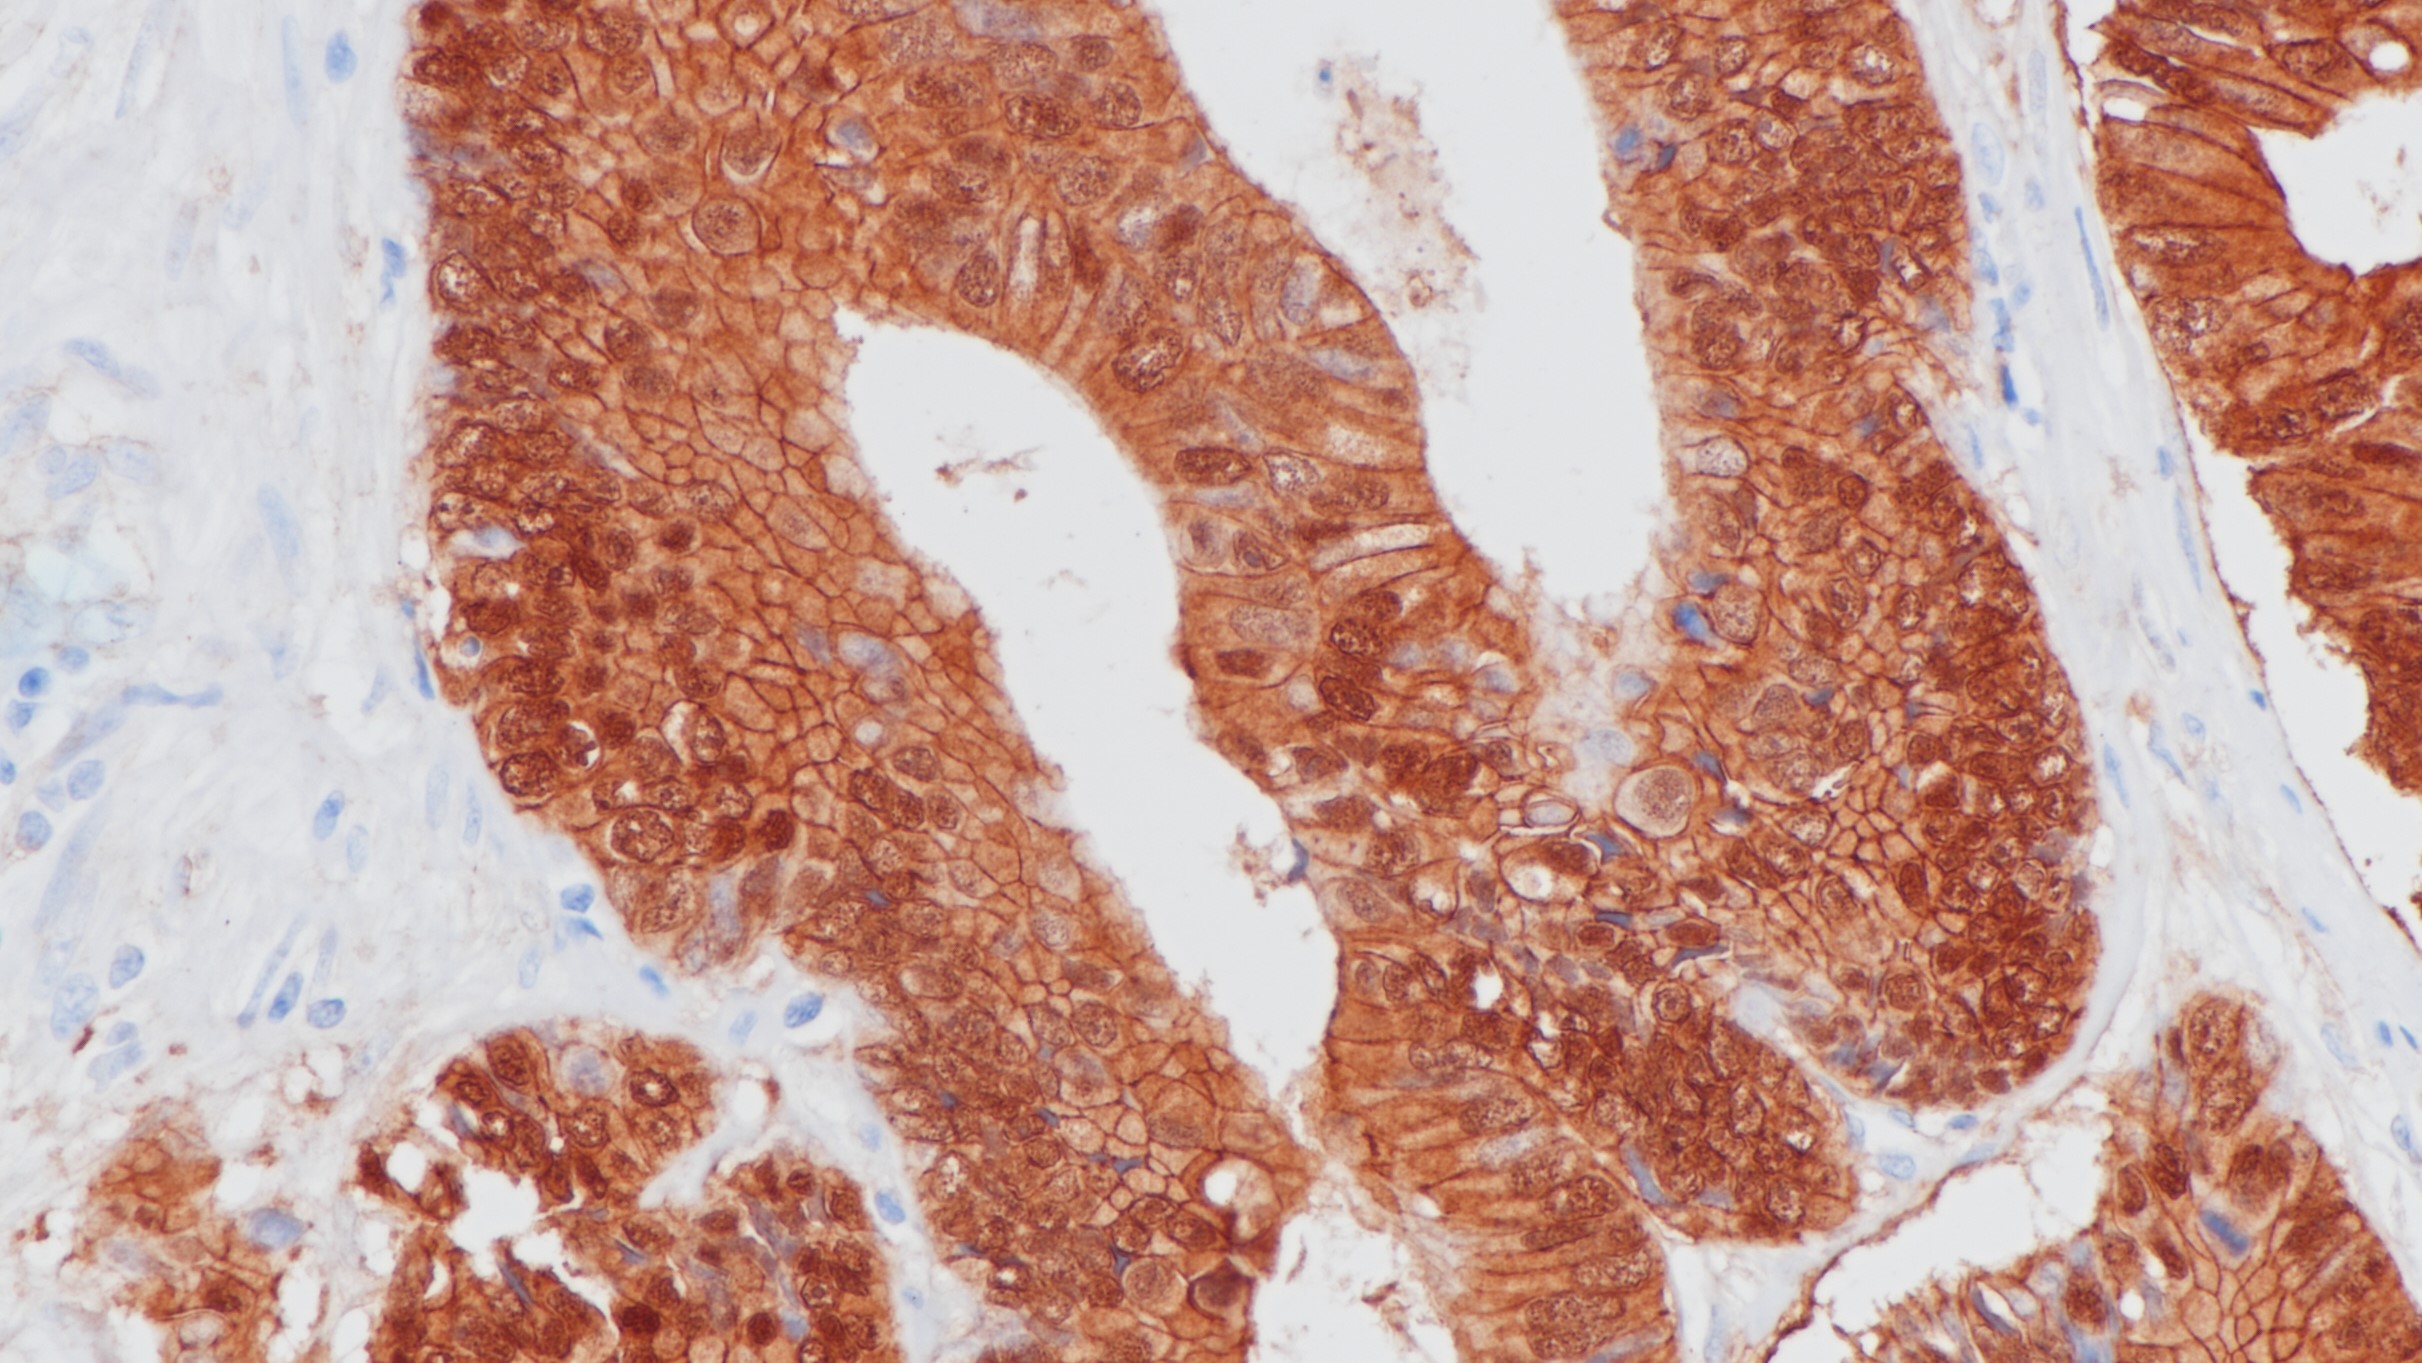
结肠癌Beta-catenin(BP6159)染色

1.马静,王凯靖,柴佳,赵丹珲,范林妮,杨重飞,刘一雄.转移性肾细胞癌组织中β-catenin表达与临床病理特征及预后的关系[J].山东医药,2020,60(14):64-66
2.Pathology & Oncology Research: Official Journal of the Arányi Lajos Foundation, 2020, Vol.26 (1), pp.533-539
3.李秀,聂敏海,刘旭倩,谭红.E-钙粘蛋白、β-连环素和基质金属蛋白酶-7与口腔鳞状细胞癌分化程度的关系[J].西南医科大学学报,2020,43(02):124-129
4.中华医学会.《临床技术操作规范·病理学分册》.人民军医出版社,2004